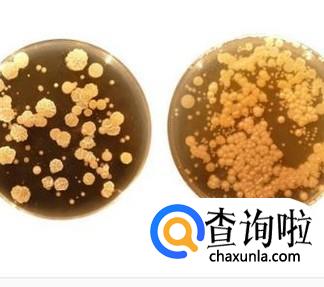

最佳回答
本文由作者推荐
详细内容
- 01
使血液变稀,浓度高的血液很黏稠,不利于血液循环,血液循环受影响时人体的稳态就会遭到破坏,从而引发一系列的症状,而吃一些大蒜,可以使血液得到稀释,因为大蒜中含有类似于维生素E和维生素C的抗氧化物质,可以氧化血液中的一些有害成分。

- 02
降低血压,(年纪太大的患者最好不要采取此方法,因为年纪太大时人体的许多组织不能承受大蒜和醋带来的刺激。)高血压患者在每天吃几瓣醋泡的大蒜,半个月后高血压患者的血压就会趋于正常状态,

- 03
降低血脂,大蒜能降低血液中的“血清总胆固醇”“甘油三脂”“脂蛋白”等物质。研究发现,平均每人每日吃20克大蒜的地区,其心血管病的死亡率明显低于无食生蒜的地区。

- 04
大蒜中的含硫化合物通过其解毒功能,从而干扰致癌物质的活化,防止癌症的形成,增强人体的免疫能力。大蒜含有的微量元素,能够杀死癌细胞,降低癌症的并发率。

- 05
大蒜有很强的抗菌消炎作用,因为大蒜中含有很多的含硫化合物,而含硫化合物具有很强的抗菌消炎作用,对多种球菌,杆菌,真菌,和病毒等都具有抑制和灭杀作用。
- 06
少数的大蒜对肝脏有益,但是肝脏患者却不宜多吃,大蒜的某些成分对于胃、肠有很强的刺激作用,会抑制肠道消化液的分泌,影响食物的消化,另外,大蒜的挥发性成分可使血液中的红细胞与血红蛋白降低,可能会引起贫血,不利于肝炎的治疗。

- 07
长期过量的吃大蒜,尤其是对于一些眼病患者和经常发烧的人来说,弊处很大,长期过量吃大蒜的人,到了五六十岁,会逐渐感到眼睛视物模糊不清,视力明显下降,耳鸣,口干舌燥,头重脚轻,记忆力明显下降。

- 08
非细菌性腹泻不宜吃大蒜,发生非细菌性肠炎,腹泻时,最好不要吃大蒜,因为肠道局部黏膜组织有炎症,辛辣的大蒜会刺激肠道,使肠道粘膜充血,水肿加重,促进渗出,使病情恶化。

工具/材料
大蒜
广告位
点击排行
- 2 排行
- 3 排行
- 4 排行
- 5 排行
- 6 排行
- 7 排行
- 8 排行
- 9 排行
- 10 排行
热点追踪
广告位





















